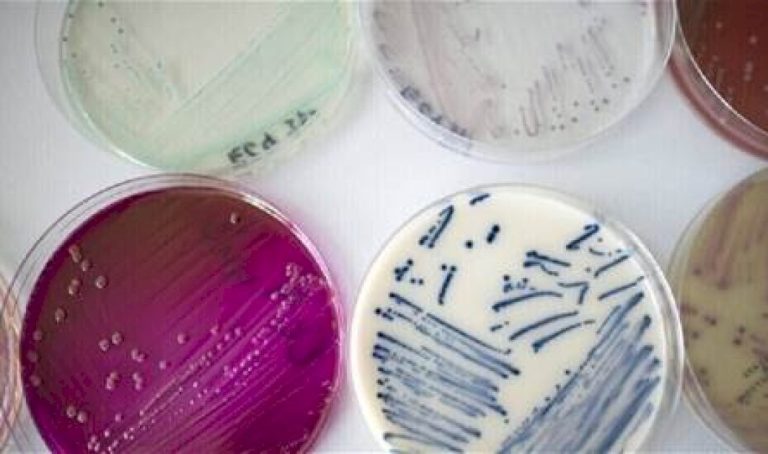
حالة مرضية ضاعفت الوفيات حول العالم في عقدٍ واحدٍ فقط! حالة-مرضية-ضاعفت-الوفيات-حول-العالم-في-عقدٍ-واحدٍ-فقط!

كشفت أحدث التقديرات العلمية الجدلية أن حوالي 3.8 مليون شخص يموتون حول العالم بسبب الالتهابات الفطرية سنويا، أي ما يمثل حوالي 6.8% من إجمالي الوفيات العالمية. ومن المحتمل أن تكون أمراض القلب التاجية مسؤولة عن 16% من إجمالي الوفيات في العالم، تليها السكتة الدماغية بنسبة 11%.
ويشكل مرض الرئة المرتبط بالدخان (COPD) 6% من إجمالي الوفيات، حيث تكون العدوى الفطرية مسؤولة عن حوالي ثلث هذه الوفيات البالغ عددها 3228000.
وأصدر الخبراء حكما بشأن نسبة الحالات الفطرية التي تم تشخيصها وعلاجها بالفعل، وتلك التي لم يتم تشخيصها. وفي حين تحسن تشخيص الأمراض الفطرية بشكل كبير في السنوات العشر إلى الخمس عشرة الماضية، فإن الوصول إلى هذه الاختبارات واستخدامها الفعلي محدود، وليس فقط في البلدان المنخفضة الدخل.
على سبيل المثال، تتمتع جنوب إفريقيا بخدمة تشخيصية تحسد عليها لالتهاب السحايا الفطري والعدوى الفطرية في مجرى الدم (المبيضات)، ولكن لا يوجد لديها تشخيص للعدوى الناجمة عن فطر شائع آخر، وهو فطر Aspergillus. وتساهم هذه الفجوات بشكل كبير في الوفيات غير الضرورية.
ويموت الكثير من الأشخاص لأن طبيبهم لم يدرك إصابتهم بمرض فطري، أو لأنهم اكتشفوا ذلك بعد فوات الأوان. ولكن العديد من الوفيات ترجع إلى بطء الاختبارات التشخيصية أو غيابها ونقص الأدوية المضادة للفطريات الفعالة.(روسيا اليوم)